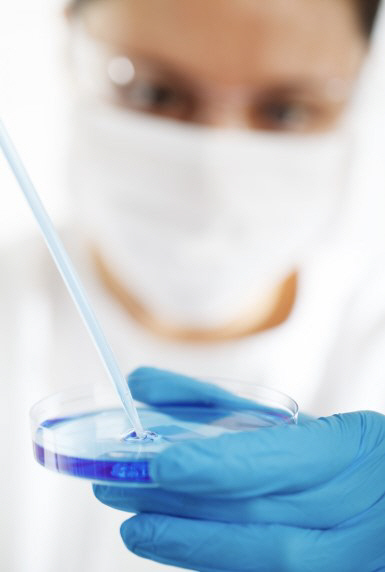

[스포츠조선 장종호 기자] 당뇨병 발병에 영향을 미치는 새로운 유전변이 145개가 발견됐다.
또한 당뇨병 유전변이를 가졌고 유전적 위험도가 '고위험군'인 사람 가운데 상위 2.5%는 일반인보다 당뇨병 발병이 2∼3년 빠른 것으로도 확인됐다.
고위험군은 당뇨병 유전변이 보유 여부 등 질환과 관련된 유전 요인으로 발병 위험도를 계산했을 때 상위 20%에 해당하는 집단이다.
국립보건연구원은 "이번 연구 결과가 유전체 분석으로 당뇨병 고위험군을 조기에 발견하는 데 활용될 수 있을 것"이라고 기대했다.
또한 심부전이나 단백뇨 등 당뇨 합병증 발생 위험을 평가하는 데에도 기여할 것으로 전망됐다. 이번 연구 결과는 국제학술지 '네이처'에 최근 게재됐다.
장종호 기자 bellho@sportschosun.com
|